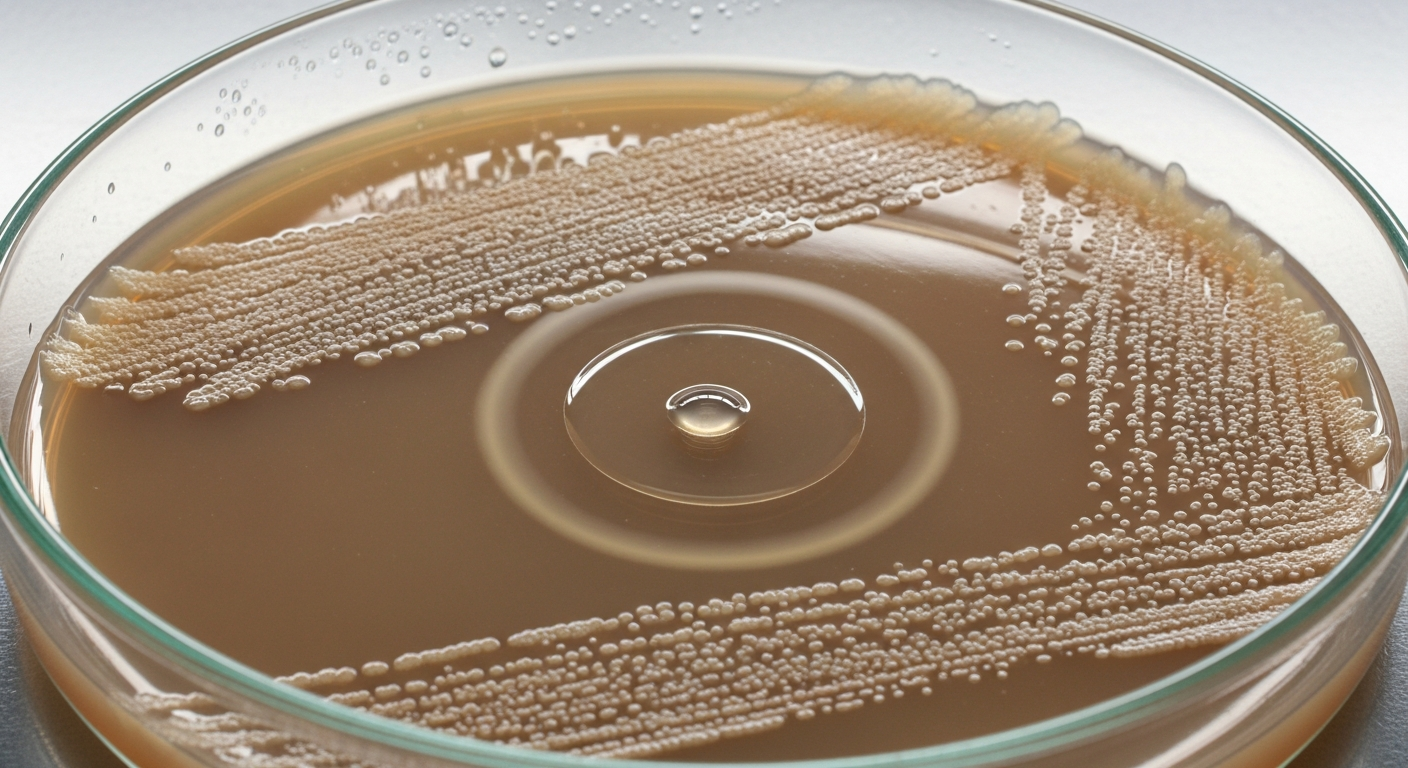

Un nouvel antibiotique surpuissant se cachait à la vue de tous depuis des décennies
Auteur: Simon Kabbaj
Introduction : un trésor redécouvert dans une bactérie ultra-connue
C’est une découverte majeure dans la lutte contre la résistance aux antibiotiques, et elle a de quoi rendre humble la communauté scientifique. Des chercheurs viennent d’identifier un nouvel antibiotique surpuissant, non pas en explorant des territoires inconnus, mais en réexaminant une bactérie que l’on étudie depuis plus de 70 ans ! Ce nouveau composé, qui se cachait ‘à la vue de tous’, pourrait devenir une arme cruciale contre les superbactéries qui menacent la santé mondiale.
La découverte : une « vraie surprise » pour les chercheurs

La découverte a été faite par une équipe de l’Université de Warwick au Royaume-Uni et de l’Université Monash en Australie. Le nouveau composé, baptisé pré-méthylènenomycine C lactone, provient d’une bactérie nommée Streptomyces coelicolor. Et c’est là que réside la surprise. « Remarquablement, la bactérie qui fabrique ces composés… est une espèce modèle productrice d’antibiotiques qui est étudiée de manière approfondie depuis les années 1950 », explique Lona Alkhalaf, chimiste à l’Université de Warwick. « Trouver un nouvel antibiotique dans un organisme aussi familier a été une vraie surprise ».
Comment ont-ils trouvé ce composé caché ?
Cette découverte est le fruit d’une idée brillante : au lieu de chercher de nouvelles molécules, les chercheurs ont décidé de regarder de plus près la ‘chaîne de montage’ d’un antibiotique déjà connu, la méthylènenomycine A, découvert il y a 50 ans. En modifiant les gènes de la bactérie, ils ont pu isoler et tester les ‘produits intermédiaires’ de cette chaîne de fabrication, des composés qui ne sont normalement que des étapes transitoires. « Alors que la méthylènenomycine A a été synthétisée plusieurs fois, personne ne semble avoir testé l’activité antimicrobienne des intermédiaires de synthèse », explique Greg Challis, un autre chimiste de l’étude. Et c’est là qu’ils ont trouvé la pépite.
Une efficacité 100 fois supérieure contre les superbactéries
Les tests en laboratoire ont révélé que ce produit intermédiaire, le pré-méthylènenomycine C lactone, était d’une puissance redoutable. Il s’est montré 100 fois plus efficace que la méthylènenomycine A elle-même contre les bactéries à Gram positif, une famille qui comprend certains de nos pires ennemis. Plus précisément, il s’est avéré efficace contre le SARM (Staphylococcus aureus résistant à la méticilline) et l’ERV (Enterococcus résistant à la vancomycine), deux des « superbactéries » qui causent le plus de problèmes dans les hôpitaux du monde entier et contre lesquelles nos antibiotiques actuels sont de moins en moins efficaces.
La promesse ultime : pas de résistance après 28 jours
Mais la découverte la plus prometteuse est peut-être celle-ci. L’un des plus grands défis avec les nouveaux antibiotiques est la vitesse à laquelle les bactéries apprennent à y résister. Les chercheurs ont donc mené un test crucial : ils ont exposé des bactéries Enterococcus au nouveau composé pendant 28 jours d’affilée. Le résultat est spectaculaire : les bactéries ne sont pas devenues résistantes. Cela suggère que cet antibiotique pourrait rester efficace sur le long terme, un avantage immense dans la lutte contre la résistance antimicrobienne, qui est déjà responsable de millions de morts chaque année.
Un « nouveau paradigme » pour la découverte d’antibiotiques ?
Cette découverte pourrait changer la manière dont on cherche de nouveaux médicaments. Au lieu de chercher de nouvelles bactéries dans des sols exotiques, les chercheurs suggèrent de revisiter les composés que nous connaissons déjà. « Cette découverte suggère un nouveau paradigme pour la découverte d’antibiotiques », déclare Greg Challis. ‘En identifiant et en testant les intermédiaires dans les voies de synthèse de divers composés naturels, nous pourrions trouver de nouveaux antibiotiques puissants avec une meilleure résilience à la résistance’. C’est une toute nouvelle bibliothèque de molécules potentiellement actives qui s’ouvre à la recherche.
Conclusion : une lueur d’espoir dans la crise des antibiotiques
Bien sûr, la route est encore longue. Le pré-méthylènenomycine C lactone doit encore passer par de nombreux tests précliniques en laboratoire pour comprendre pleinement son potentiel, ses mécanismes d’action et les cibles qu’il peut atteindre. Mais cette découverte, publiée dans le Journal of the American Chemical Society, est une immense lueur d’espoir. Elle nous prouve que des solutions à l’une des plus grandes crises sanitaires de notre temps se cachent peut-être juste sous notre nez, dans des connaissances que nous pensions acquises. Parfois, pour faire un grand pas en avant, il suffit de regarder en arrière avec des yeux neufs.










